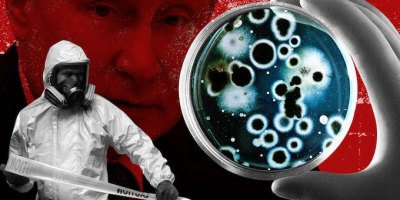

Auteur : lecridespeuples
1860 Posts


Moscou : en ciblant la centrale nucléaire de Zaparojie, Kiev pousse l’Europe au bord du gouffre

Commerce du gaz : la Russie enseigne le B-A-BA à l’Europe
La Russie accuse les Etats-Unis d’avoir créé le Covid-19

A Taïwan, Nancy Pelosi a bravé le dragon chinois mais a-t-elle gagné ?

Tensions Russie-Israël : Moscou expulse l’Agence juive mondiale

Article de Sergueï Lavrov : Les mises en scène en tant que méthode de la politique occidentale

Poutine révèle les véritables causes de la crise énergétique en Europe

Situation en Ukraine : conférence de presse de Maria Zakharova, porte-parole du Ministère des affaires étrangères russe
